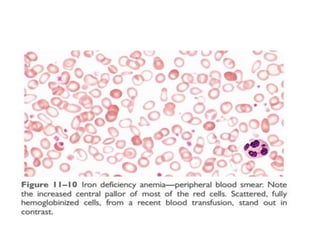
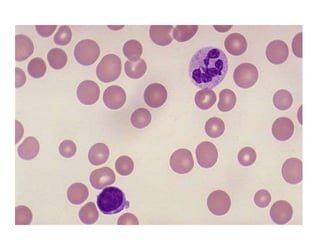
Anemia.pptx

The document outlines various types of anemia, including iron deficiency anemia, anemia of chronic disease, folate deficiency anemia, and vitamin B12 deficiency anemia. Each type is characterized by specific causes, pathology, clinical features, and diagnostic criteria. It emphasizes the importance of understanding the mechanisms and manifestations of these conditions to facilitate appropriate diagnosis and treatment.